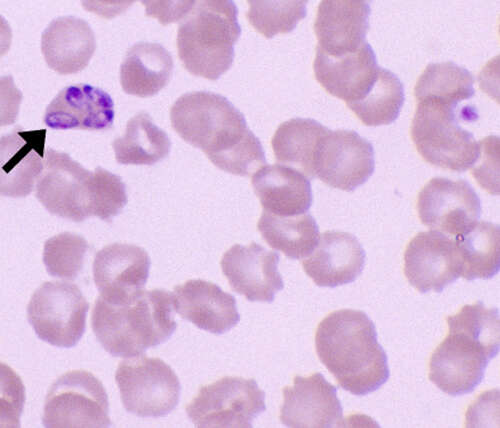

Regular diagnostic testing is essential for detecting, monitoring, and managing your pet’s health. Whether your pet is young, senior, or showing signs of illness, laboratory tests provide valuable insights that help veterinarians make accurate and timely decisions.
At VetLesions Veterinary Diagnostic Laboratory, we support veterinarians and pet parents with a wide range of reliable tests tailored specifically for dogs and cats. Below is a guide to the most commonly recommended diagnostic tests and what they reveal.
- Complete Blood Count (CBC) The CBC is the most fundamental health screen. It looks at red blood cells (which carry oxygen), white blood cells (the body’s “soldiers” against infection), and platelets (which help with clotting). It’s our first line of defense in spotting anemia, hidden infections, or underlying inflammation.

What it helps detect:
- Infections
- Anemia
- Immune system disorders
- Inflammation and blood-related conditions
Why it is important:
-
It provides a quick overall picture of your pet’s health
-
Helps identify infections and inflammation early
-
Detects anemia and blood-related disorders
-
Assesses how well the immune system is functioning
-
Guides treatment decisions and further testing
A CBC is often the first test recommended when a pet appears unwell because it can reveal hidden problems and help veterinarians act before a condition becomes serious. It is also valuable for routine health checks, monitoring ongoing illnesses, and ensuring pets are fit for surgery or treatment.
In simple terms, a CBC helps catch problems early—when they are easiest to manage and treat—supporting a healthier, longer life for your pet.
- Biochemistry Panel

Why it is important:
-
Assesses kidney and liver function
-
Helps diagnose diabetes and pancreatic disorders
-
Detects electrolyte and metabolic imbalances
-
Identifies early signs of chronic disease
-
Supports safe anesthesia and treatment planning
This test is especially important for senior pets, pets showing vague symptoms like weight loss or lethargy, and for routine health screenings. By identifying problems early, a biochemistry panel allows veterinarians to start timely treatment and monitor long-term health more effectively—helping your pet live a healthier, more comfortable life.
- Heartworm Test (Dogs)

Why it is important:
-
Detects heartworm infection before severe symptoms appear
-
Prevents irreversible heart and lung damage
-
Allows early treatment, which is safer and more effective
-
Helps ensure heartworm prevention is working
-
Recommended annually for all dogs, even those on preventives
Heartworm disease often shows no early signs, making routine testing critical. Early detection protects your dog from serious complications and supports a long, healthy life through timely prevention and treatment.
- Fecal Examination (Stool Test)

Purpose:
Detects internal parasites such as worms and protozoa.
What it helps detect:
- Roundworms, hookworms, and tapeworms
- Giardia and coccidia
Why it is important:
-
Detects worms and intestinal parasites early
-
Helps prevent digestive issues like diarrhea and weight loss
-
Protects puppies, kittens, and senior pets who are more vulnerable
-
Prevents spread of parasites to other pets
-
Reduces the risk of parasite transmission to humans
Regular fecal testing supports your pet’s digestive health and helps keep your home and family safe. Early detection allows simple, effective treatment before parasites cause serious health problems.
- Urinalysis

What it helps detect:
- Urinary tract infections (UTIs)
- Kidney disease
- Crystals or bladder stones
- Early signs of diabetes
- Thyroid Function Test (T4) A thyroid function test measures thyroid hormone levels and helps evaluate how well the thyroid gland is working. Thyroid hormones play a key role in regulating metabolism, energy levels, and overall body function.

Why it is important
-
Detects hypothyroidism in dogs, a common condition causing weight gain, lethargy, and skin issues
-
Identifies hyperthyroidism in cats, especially senior cats, which can lead to weight loss and increased appetite
-
Helps explain unexplained behavioral or energy changes
-
Supports accurate diagnosis and long-term treatment planning
-
Enables monitoring of ongoing thyroid therapy
Thyroid disorders often develop gradually and may be mistaken for normal aging. Early testing ensures timely treatment, helping your pet maintain a healthy weight, energy level, and quality of life.
- Low T4 (Hypothyroidism) — Common in dogs; may cause weight gain, lethargy, and skin problems.
- High T4 (Hyperthyroidism) — Common in senior cats; may lead to weight loss, increased appetite, and restlessness.